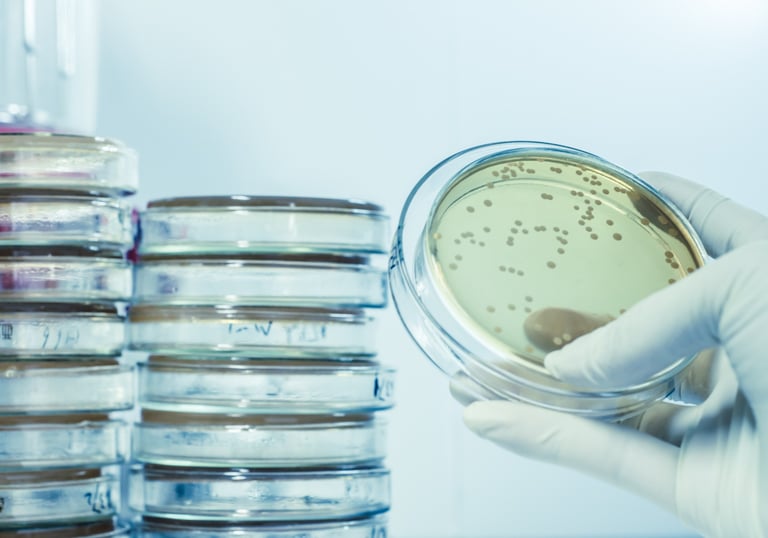
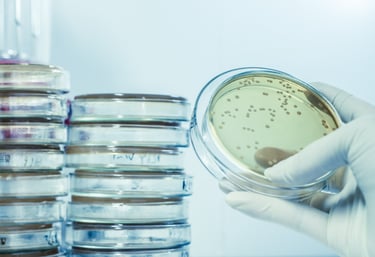

Conceptual & Detailed Designs
Translating requirements into specs.
Conceptual and detailed engineering designs, validated through rigorous specifications, dimensioning and models.


3D Irradiance & Dose Simulations
For Surfaces, Whole Rooms, AirLock, Tunnels.
3D irradiance and dose simulations to simulate UV-C light behavior and distribution,with safety and aging factors.
Specialized masterclasses (virtual, on-site).
Covering fundamental principles, application rules, safety protocols and design brainstorm for all stakeholders.
Masterclasses - Entry & Advanced

Irradiance & Dose Checks, Audits
On-site radiometry and safety audits (expert checklists for safe design / deployment).
Precise execution following exhaustive protocols to verify real-world system performance against design specifications.
Microbiology - Knowledge & Test
Dose vs Log-reduction data, Protocol Setup.
Own database of real-life applications UV-C light doses (@254nm) to achieve various log-reductions on microorganisms (bacteria, spore-forming bacteria, fungi, virus, etc.).





